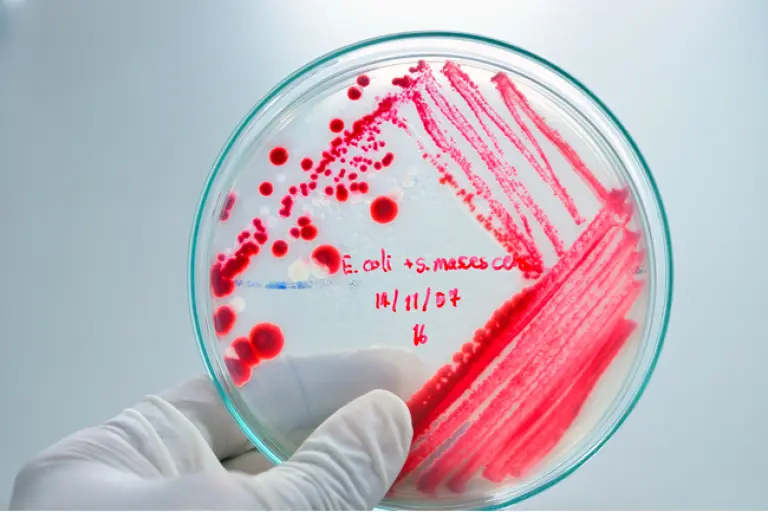
main image

Lectura 4:00 min
¿Realmente puede existir un antibiótico infalible?
La búsqueda de nuevos antibióticos no debe detenerse, ya que alguna bacteria desarrollará resistencia.
Después del anuncio de un nuevo antibiótico llamado teixobactin y sus aparentes cualidades de destructor de superbacterias , pues no genera resistencia detectable de las mismas, las opiniones han sido alentadoras; sin embargo, Tim Sandle, biólogo con más de 25 años de experiencia en la investigación microbiológica y procesamiento biofarmacéutico, aseguró que es importante considerar el antibiótico, pero no necesariamente como la salvación del futuro.
En el artículo Los mitos en torno al teixobactin , publicado en el Digital Journal, Sandle destaca que la investigación en sí misma es relevante, ya que no se había descubierto una nueva clase de antibióticos desde 1987 y que esto es muy importante, porque la crisis de la resistencia a los antibióticos es la mayor amenaza, dentro del campo de la ciencia y la medicina, que enfrenta la humanidad .
Es importante destacar que los antibióticos ayudan a reducir el riesgo de complicaciones potencialmente peligrosas para la vida en la cirugía, la quimioterapia y el trasplante. La crisis de antibióticos ha surgido debido a que microbios patógenos continúan creciendo después de la exposición a uno o más agentes antimicrobianos, debido a las modificaciones genéticas que confieren resistencia , continúa el biólogo.
Esto significa que una bacteria se puede volver resistente a múltiples antibióticos y este proceso continúa hasta que no hay antibióticos efectivos.
El autor explica que la razón por la cual no hay nuevos antibióticos es que las compañías farmacéuticas pasaron por un periodo de no investigar debido a la muy baja rentabilidad de la inversión. Esto cambió un poco hace unos años, cuando se vieron obligados los gobiernos, como resultado de la crisis, a incentivar a las grandes compañías farmacéuticas, sin embargo, la mayor parte de la nueva investigación, incluyendo teixobactin, ha surgido del sector universitario , continúa.
¿Son medios de comunicación? o lo son de mitificación?
El verdadero problema, explica Sandle, es que los medios de comunicación han presentado el antibiótico como si fuese algo superresistente, como para dar a entender que ninguna bacteria en el futuro será capaz de desarrollar resistencia en contra. Esto no tiene sentido palpable, nadie lo sabe, y la teoría microbiológica que prevalece es que un día una especie bacteriana desarrollará resistencia. Ésta es la razón por la que la búsqueda de nuevos antibióticos debe ser continua , aclaró.
Estoy emocionado por el teixobactin, creo que representan un paso adelante, sin embargo, se necesita más investigación y se requiere mucha más prudencia por parte de los agricultores, los médicos y los pacientes en el uso de antibióticos , concluyó.
Descubren antibiótico que no desarrolla resistencia
Londres, Ing. Científicos descubrieron un nuevo antibiótico, el teixobactin, que elimina las infecciones graves en ratones sin generar resistencia detectable en las primeras etapas, lo que ofrece potencial para una nueva forma de tratar a peligrosas superbacterias.
Los investigadores dijeron que el antibiótico, que todavía debe ser probado en humanos, podría ser usado algún día para tratar infecciones causadas, por ejemplo, por el Estafilococus aureus, resistente a la meticilina, o el Mycobacterium tuberculosis, que actualmente requiere de una combinación de medicamentos que pueden tener efectos adversos.
El hallazgo de este nuevo componente desafía las creencias científicas de larga data y ofrece una enorme promesa para el tratamiento de infecciones amenazadoras y resistentes , dijo Kim Lewis, profesor de la Northeastern University en Estados Unidos y cofundador de NovoBiotic Pharmaceuticals, empresa que patentó el teixobactin.
Lewis trabajó con investigadores de la Universidad de Bonn en Alemania y con la firma británica Selcia Limited, y los resultados de su estudio fueron publicados en la revista científica Nature.
Su compañera en el estudio, Tanya Schneider, de la Universidad de Bonn, explicó que el teixobactin pertenece a una nueva clase de compuestos y que mata a una bacteria causando la destrucción de sus paredes celulares.
Parece trabajar al vincular una serie de blancos a atacar, dijo, lo que podría desacelerar el desarrollo de resistencia.
El problema de las infecciones que desarrollan resistencia a los fármacos cosa que sucede desde el descubrimiento del primer antibiótico, la penicilina ha empeorado en los últimos años por la aparición de superbacterias que no son afectadas por múltiples medicamentos. (Con información de Reuters)